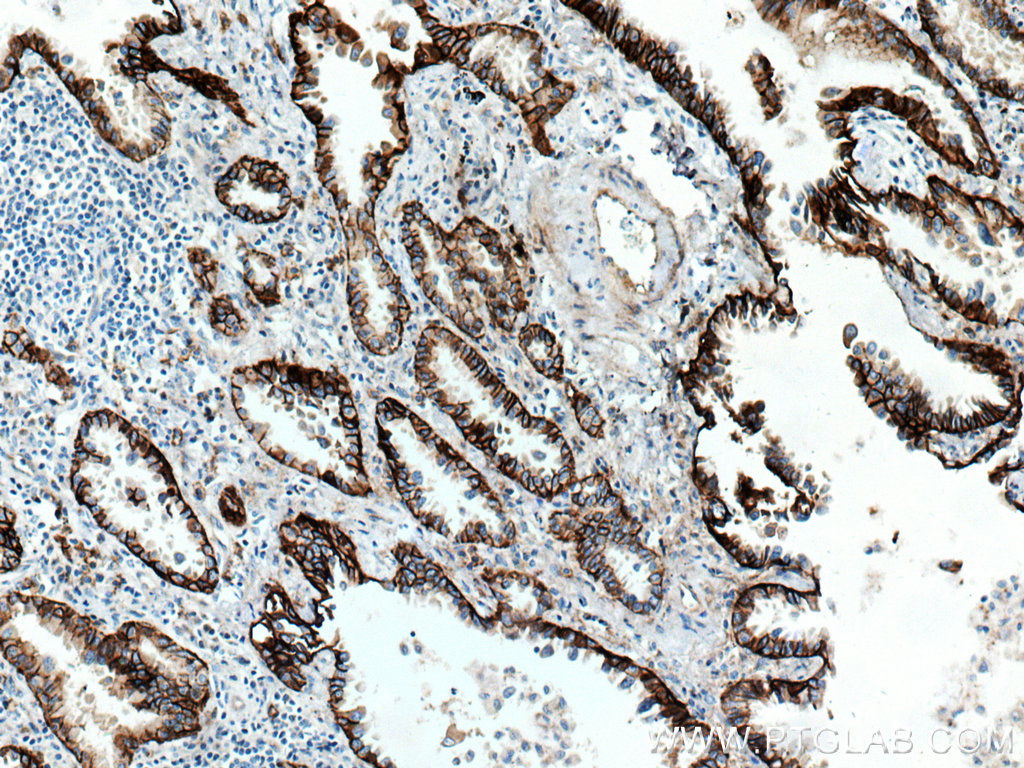

验证数据展示
产品信息
66070-1-PBS targets Integrin Alpha 3 in WB, IHC, Indirect ELISA applications and shows reactivity with human, pig, mouse samples.
| 经测试应用 | WB, IHC, Indirect ELISA Application Description |
| 经测试反应性 | human, pig, mouse |
| 免疫原 |
CatNo: Ag17293 Product name: Recombinant human Integrin alpha-3 protein Source: e coli.-derived, PGEX-4T Tag: GST Domain: 52-376 aa of BC150190 Sequence: FGYSVALHRQTERQQRYLLLAGAPRELAVPDGYTNRTGAVYLCPLTAHKDDCERMNITVKNDPGHHIIEDMWLGVTVASQGPAGRVLVCAHRYTQVLWSGSEDQRRMVGKCYVRGNDLELDSSDDWQTYHNEMCNSNTDYLETGMCQLGTSGGFTQNTVYFGAPGAYNWKGNSYMIQRKEWDLSEYSYKDPEDQGNLYIGYTMQVGSFILHPKNITIVTGAPRHRHMGAVFLLSQEAGGDLRRRQVLEGSQVGAYFGSAIALADLNNDGWQDLLVGAPYYFERKEEVGGAIYVFMNQAGTSFPAHPSLLLHGPSGSAFGLSVASI 种属同源性预测 |
| 宿主/亚型 | Mouse / IgG2a |
| 抗体类别 | Monoclonal |
| 产品类型 | Antibody |
| 全称 | integrin, alpha 3 (antigen CD49C, alpha 3 subunit of VLA-3 receptor) |
| 别名 | CD49C, FRP 2, Galactoprotein B3, GAP B3, GAPB3, Integrin alpha 3, ITGA3, MSK18, VCA 2, VL3A, VLA 3 subunit alpha, VLA3a |
| 计算分子量 | 1066 aa, 119 kDa |
| 观测分子量 | 120 kDa |
| GenBank蛋白编号 | BC150190 |
| 基因名称 | Integrin alpha 3 |
| Gene ID (NCBI) | 3675 |
| RRID | AB_11042765 |
| 偶联类型 | Unconjugated |
| 形式 | Liquid |
| 纯化方式 | Protein A purification |
| UNIPROT ID | P26006 |
| 储存缓冲液 | PBS only, pH 7.3. |
| 储存条件 | Store at -80°C. The product is shipped with ice packs. Upon receipt, store it immediately at -80°C |
背景介绍
ITGA3, also named as MSK18, CD49c, GAPB3 and FRP-2, belongs to the integrin alpha chain family. It is a receptor for fibronectin, laminin, collagen, epiligrin, thrombospondin and CSPG4. ITGA3 may mediate with LGALS3 the stimulation by CSPG4 of endothelial cells migration. ITGA3 is highly concentrated in epithelial cells where it strongly adheres to Laminin-5 and Laminin-5 induced rapid adhesion can be blocked by antibodies against the alpha-3 integrin subunit. It can be cleaved into heavy chain(840aa) and light chain(176aa). This antibody can recognize the heavy chain.